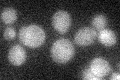
YOL025W
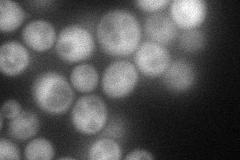
YOL025W
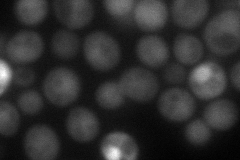
YOL025W

View description
Protein that negatively regulates the SCF E3-ubiquitin ligase by interacting with and preventing neddyation of the cullin subunit, Cdc53p; longevity determinant that is preferentially expressed in young cells; similar to mammalian Cand1
Localization:
Intensity:
Fold change:
Significance:
-
C’ GFP library in SD
below threshold17.26 -
N' NOP1pr-GFP in SD
cytosol,nucleus61.3316 -
N' TEF2pr-mCherry in SD
nucleus82.3398 -
N' NATIVEpr-GFP in SD

below threshold27.2789 -
N' TEF2pr-VC and Cyto-VN in SD

#N/A0 -
C’ GFP library in SD+DTT

cytosol15.260.88No -
C’ GFP library in SD+H2O2

cytosol20.571.19No -
C’ GFP library in Starvation Media

cytosol15.370.88No -
C’ GFP library on the background of Pup2-DaMP

below threshold -
C’ GFP library on the background of CCT mutant

below threshold18.55161.07411No
